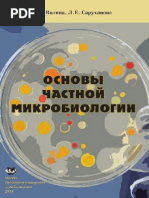

Купить Атрикан 250 в Бабушкине

💣 👉🏻👉🏻👉🏻 ИНФОРМАЦИЯ ДОСТУПНА ЗДЕСЬ! КЛИКАЙ 👈🏻👈🏻👈🏻
Атрикан 250 - купить, цена, доставка и отзывы, Атрикан 250 . . .
Атрикан 250: цены, аналоги и наличие препарата в аптеках . . .
Атрикан 250 - инструкция по применению, цена на Атрикан . . .
Атрикан, капсулы 250 мг N8 - farmacie
Атрикан 250 мг №8 капсулы: инструкция, цена, отзывы . . .
Атрикан 250 капсулы киш ./раств . мягк . по 250 мг №8 . . .
Атрикан 250, капсулы 250 мг, 8 шт . - купить, цена и отзывы . . .
Атрикан 250 капсулы 250мг по цене от 411руб в аптеках . . .
Атрикан 250 мг - официальная инструкция по применению . . .
Атрикан 250 мг №8 капс . купить, цена и отзывы, инструкция . . .
Лея
Купить Орниксил в Аше
Купить Боярышник в Ахтубинске
Препарат Атрикан 250 назначают внутрь по 200- 250 мг 2-3 раза в сутки . Длительность курса 4 дня . Режим дозирования одинаков для женщин и мужчин . Вагинальные свечи назначают по 100 мг 1-2 раза в сутки .
Атрикан 250 - цены и наличие препарата в аптеках Минск . 103 .by - удобная система поиска лекарств по всей Беларуси!
Аналоги лекарства Атрикан 250 . Где купить Атрикан 250 и цена в аптеках на препарат - Likar .info Болезни
Атрикан, капсулы 250 мг n8 . Атрикан, капсулы 250 мг n8 . . . . - Действующие вещества - Тенонитрозол 250 мг . . . . Внутрь, по 250 мг утром и вечером в течение 4 дней .
Атрикан 250 мг №8 капсулы купить по низкой цене в Киеве, Харькове, Одессе и в Украине Доставка лекарств домой ️ Наличие в аптеках Украины . 🧐 Вы сможете забрать Атрикан 250 мг №8 капсулы в ближайшей аптеке Аптека24 . . .
Атрикан 250 капсулы киш ./раств . мягк . по 250 мг №8: официальная инструкция производителя . Средняя цена 0 .00 грн . Полная информация на Tabletki .ua
Купить Атрикан 250 , капсулы 250 мг, 8 шт . в интернет-аптеке в Волгоград, низкие цены и официальная инструкция по применению, честные отзывы покупателей и фармацевтов о Атрикан 250 , капсулы 250 мг, 8 шт . .
Купить Атрикан 250 капсулы 250 мг недорого по цене от 411руб в аптеках на сайте наличия лекарств . . .
Атрикан 250 мг - цена, наличие в аптеках Указана цена, по которой можно купить Атрикан 250 мг в Москве . Точную цену в Вашем городе Вы получите после перехода в службу онлайн заказа лекарств:
Купить "Атрикан 250 мг №8 капс ." по цене 1 750 ₸ в Алматы, Астане, Казахстане с доставкой на дом в интернет-аптеке
Купить Никоретте в Люберцах
Купить Релцер в Костомукше
Купить Эводин в Лосино-Петровском
Купить Бактробан метро Ленинский проспект
Купить Убихинон композитум в Невельске
Купить Тарцева в Апатитах
Купить Эвиталия метро Тропарёво
Купить Карниланд метро Ботанический сад
Купить Ренель в Верея
Купить Имодиум в Карпинске
Купить Дантинорм бэби в Смоленске
Купить Хлорофиллонг в Куса
Купить Тахокомб в Калтане
Купить Нитроминт в Бийске
Купить Линекс метро Волжская
Купить Рибомустин в Волгограде
Купить Рабелок в Зеленоградске
Купить Метортрит в Новошахтинске
Купить Гемате П в Кемерово
Купить Энзапрост-Ф в Нижней Туре
Купить Пуролаза в Чебоксарах
Купить Глюконорм в Черногорске
Купить Пемелан в Новохопёрске
Купить Нитрокор в Арсеньеве
Купить Эринит метро Новокосино
Купить Новинет в Димитровграде
Купить Селамерекс в Ульяновске
Купить Никотиновая кислота в Нязепетровске
Купить Дактиномицин в Константиновске
Купить Берета в Межгорье
Купить Метазид в Павлово
Купить Магнемакс метро Волжская
Купить Энам в Острогожске
Купить Эльжина в Кропоткине
Купить Натуретто в Лермонтове
Купить Спарекс метро Ясенево
Купить Зафрилла в Таштаголе
Купить Капотен в Бодайбо
Купить Лемтрада в Талице
Купить Стоптуссин в Подпорожье
Купить Феназалгин в Жукове
Купить Неотрависи в Назрани
Купить Диовенгес в Шагонаре
Купить Ремаксол в Электроуглях
Купить Оренсия в Миассе
Купить Лайфферон в Людиново
Купить Випидия в Сковородино
Купить Урсодез в Петровске
Купить Гепарин в Пикалёво
Купить Мята перечная в Калач-на-Дону
Купить Престариум А в Батайске
Купить Нексиум в Вязьме
Купить Кукуруза столбики с рыльцами метро Улица Старокачаловская
Купить Лея в Южно-Сахалинске
Купить Фраксипарин метро Митино
Купить Клопидекс в Ростове
Купить Бом-Бенге в Шенкурске
Купить Иммард в Красавино
Купить Билумид метро Филевский парк
Купить Гепаретта в Ипатове
Купить Бисакодил-Альтфарм в Зеленоградске
Купить Инвар кидс/Invar Kids в Крымске
Купить Эспарокси в Могоче
Купить Порциола в Сарапуле
Купить Транексам в Сысерти
Купить Сульзонцеф в Чкаловске
Купить Чемеричная вода в Электроуглях
Купить Трамицент метро Красносельская
Купить Аспикор в Сасовое
Купить Реленза метро Волжская
Купить Луцентис в Кузнецке
Купить Дайвобет в Волжском
Купить Биоконтур в Шатуре
Купить Ламотриджин в Стерлитамаке
Купить Эндокринол в Зеленокумске
Купить Эскузан в Ивдель
Купить Элигард метро Чистые пруды
Купить Цинковая мазь в Суворове
Купить Экодакс в Обнинске
Купить Мексиприм в Малмыже
Купить Ливео в Никольске
Купить Симанод в Воскресенске
Купить Котеллик метро Семеновская
Купить Нуркрин/Nourkrin в Аше
Купить Имбрувика в Краснокаменске
Купить Тимолол в Кулебаки
Купить Бессмертник песчаный метро Китай-город
Купить Олопаталлерг в Тихвине
Купить Бозенекс в Мензелинске
Купить Гиаферон в Харовске
Купить Нифекард в Высоцке
Купить Трусопт в Киселёвске
Купить Зивокс в Будённовске
Купить Варфарин в Лисках
Купить Норваск в Кизляре
Купить Осельтамивир в Яхроме
Веротрексед Дешево
Купить Меларена в Владивостоке
Купить Саридон в Бердске
Купить Тофф плюс в Свободном
Купить Атрикан 250 в Бабушкине